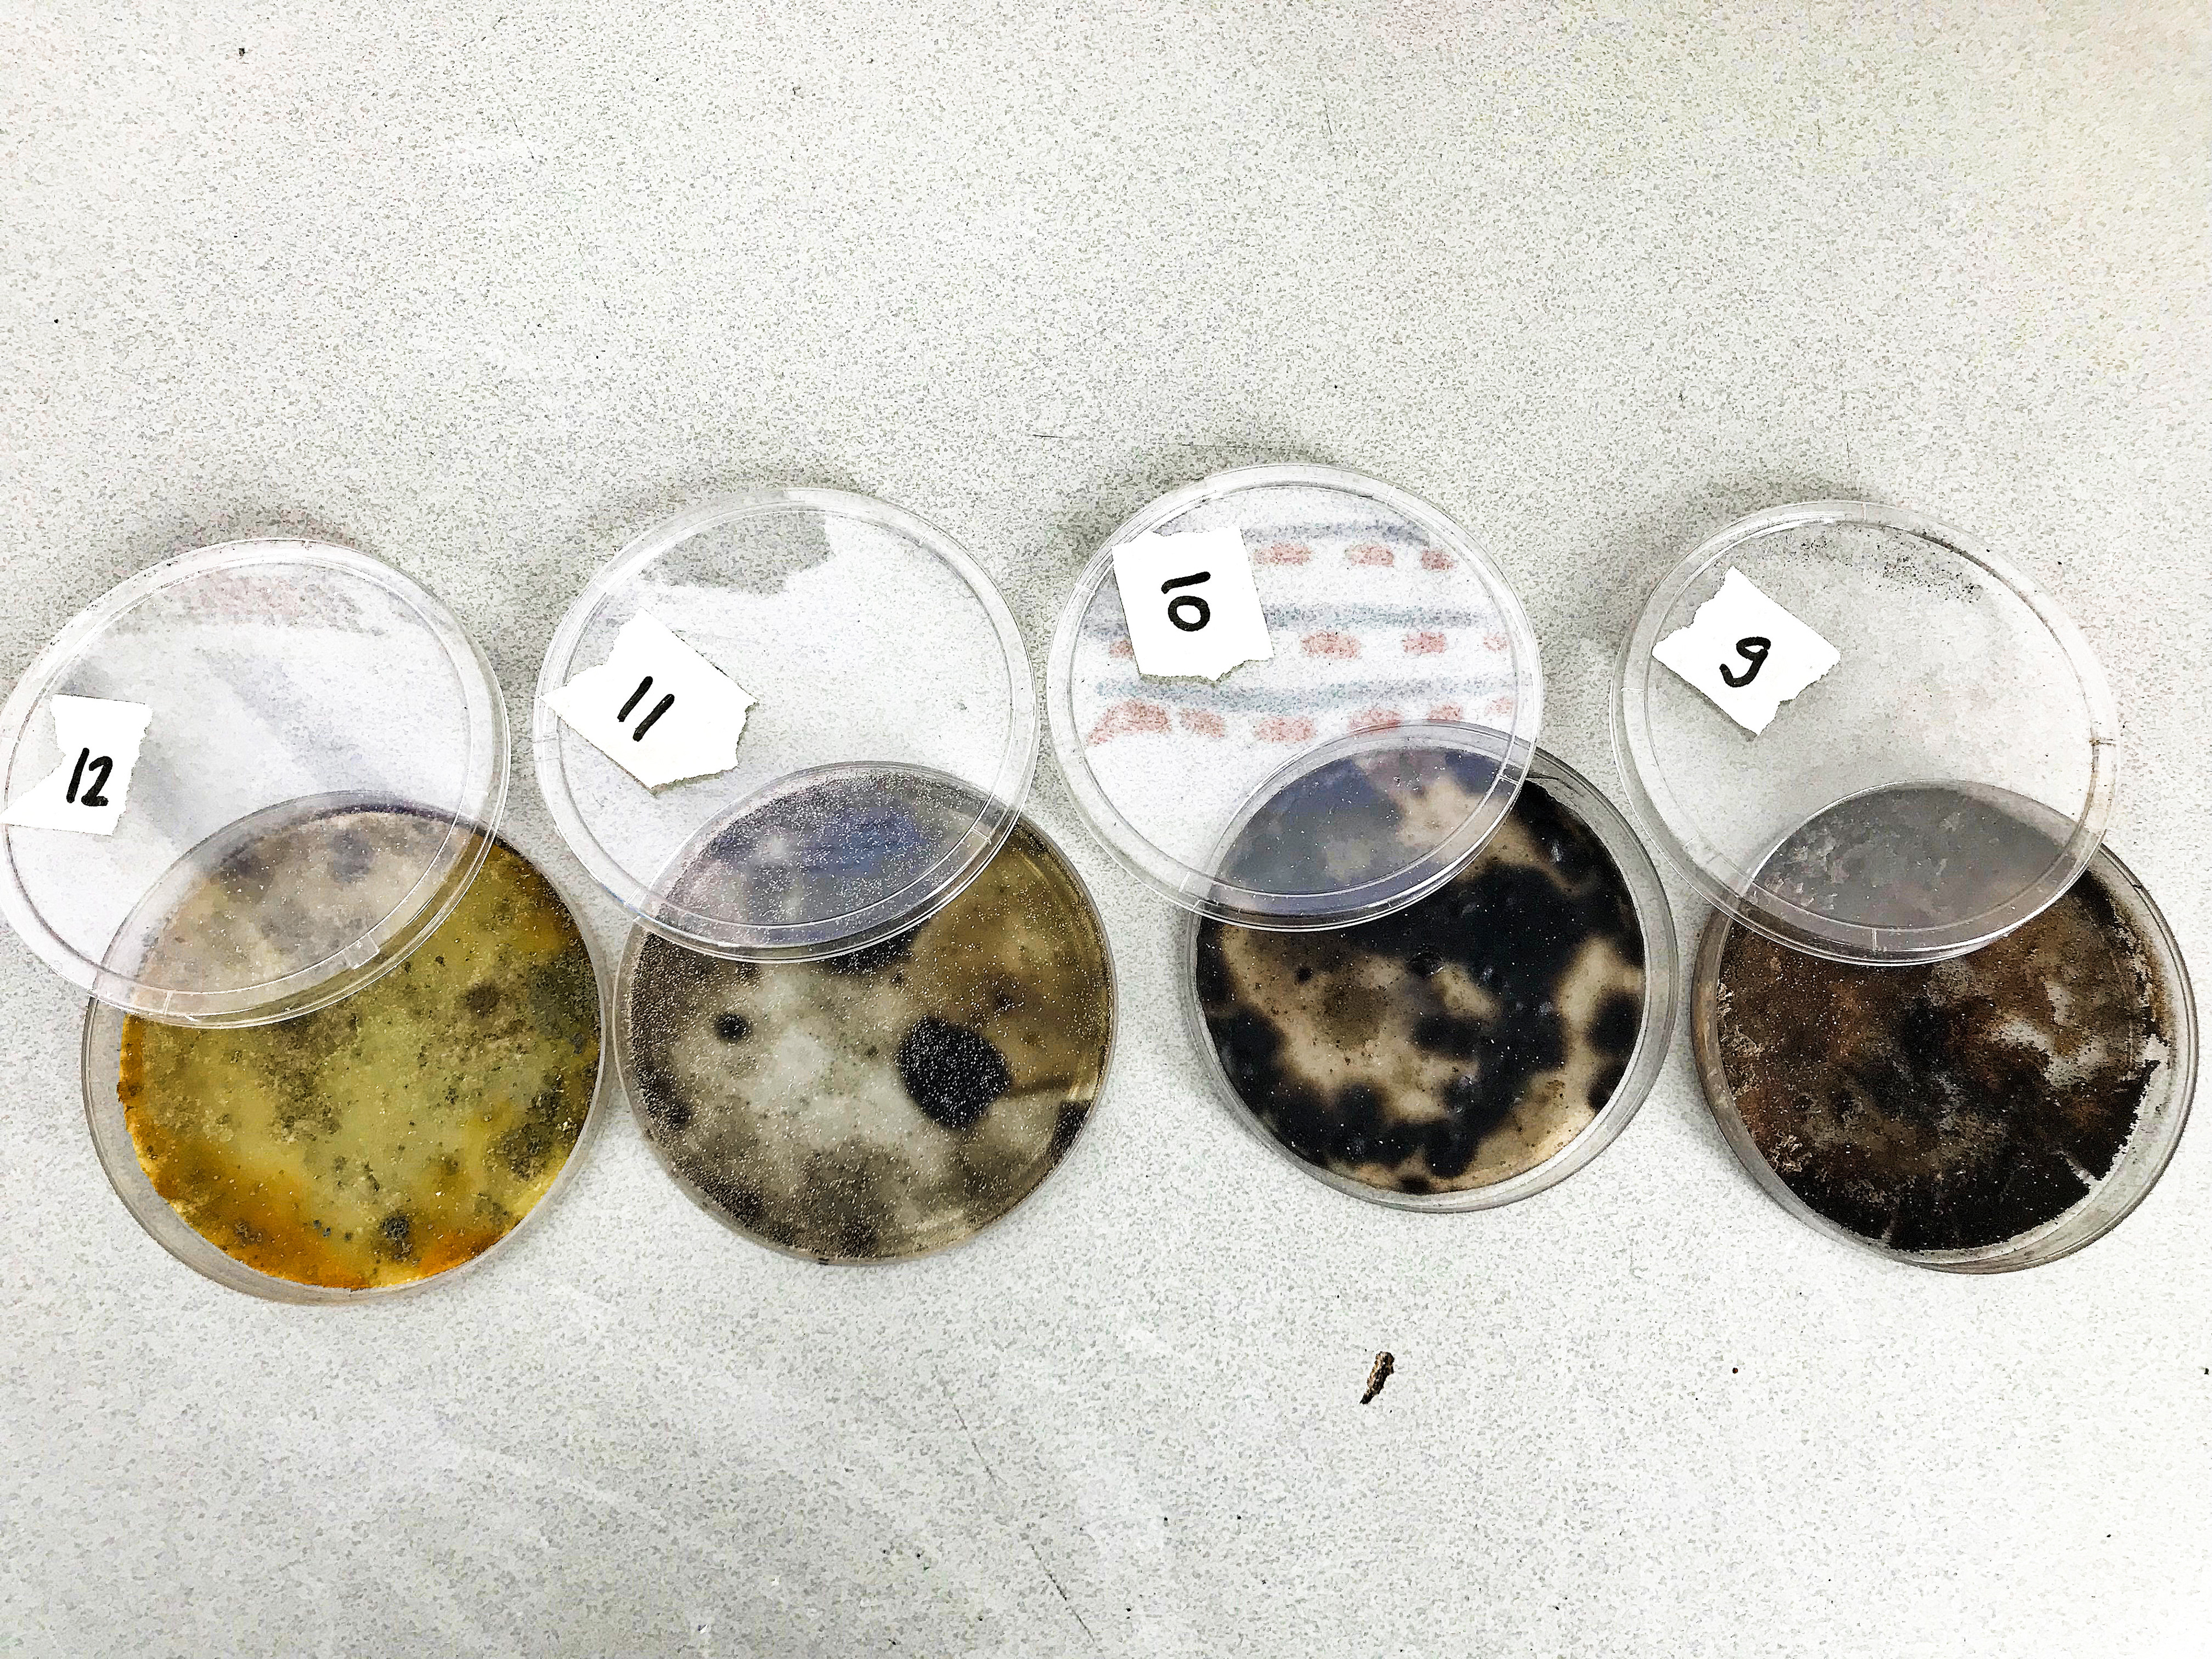

In these petri dishes I have added different types of sugars to see what influence that has on the growth process


In this project I started researching fungi. How does it grow and can you speed up this process.
In these petri dishes I have added different types of sugars to see what influence that has on the growth process